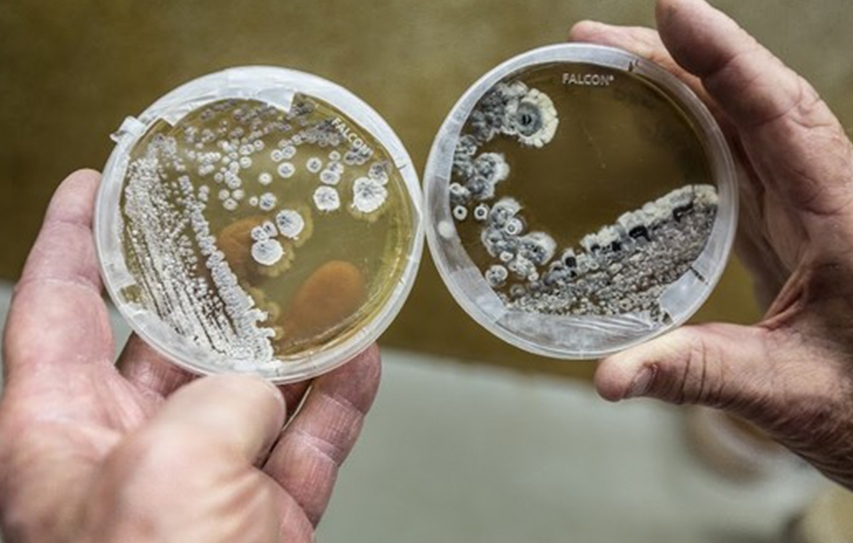

Breaking News
- Retroscope
RETROSCOPE: CELEBRATING THE LEGEND DARA SINGH
0 - Alternative Entertainment
ALTERNATIVE ENTERTAINMENT: GHATAK, JUNG, BRECHT & PARTITION
0 - Powerful People
POWERFUL PEOPLE: JUST DO IT
0 - TV
TV: A JOURNEY THROUGH GOD’S OWN COUNTRY
0 - Bollywood
BOLLYWOOD: HAQ AND THE PRICE OF A WOMAN’S VOICE
0 - Festivals
FESTIVALS: THE POWER OF CREATIVE PARTNERSHIPS
0 - Festivals
FESTIVALS: PRITHVI FESTIVAL 2025 IGNITES MUMBAI
0 - Business and Politics
BUSINESS: ROHIT ARYA & WHEN DREAMS TURN DESPERATE
0 - Festivals
FESTIVALS: BRIDGES OF ART CONNECT WORLDS
0 - Bollywood
BOLLYWOOD: WHEN THE STAR MEETS A MEMORY
0
news
How Worried Should We Be About The 'Nightmare Bacteria' Making Headlines?
“It’s not that this bacteria is highly transmissible,” said Dr. Emil Lesho, director of WRAIR’s Multidrug-resistant Organism Repository and Surve...
Read MorePlants Know When They’re Being Touched
By and large, most research seeking to attribute a mental life to plants has been discredited over the years. Yet new research coming out of the University of Western Australi...
Read MoreFilmOut, San Diego’s LGBT Film Festival, Kicks Off Friday
San Diego’s LGBT Film Festival, FilmOut, kicks off its 18th year Friday at the Observatory in North Park. This year, FilmOut had nearly 900 film submissions that had to ...
Read MoreOntario Place To Host Arts And World Music Festival In September
For the first time since 2012, Toronto's Ontario Place will be fully open to the public later this year for the staging of an arts and world music festival.Ontario Place will ...
Read MoreBollywood Actress Jacqueline Supports UN Campaign Against Illegal Wildlife Trade.
United Nations: Bollywood actress Jacqueline Fernandez, Brazilian supermodel Gisele Bundchen among others are lending their support to a global campaign launched by the United...
Read MoreUsher Joins Sugar Ray Leonard At Star-Studded Big Fighters, Big Cause Charity Boxing Night
The B. Riley & Co. 7th Annual “Big Fighters, Big Cause” Charity Boxing Night returned to The Ray Dolby Ballroom at Hollywood & Highland on Wednesday, May 2...
Read MoreWorld No-Tobacco Day: Rules Are In Place But No Enforcement?
Every day, we witness some 10-15 cancer cases which are tobacco related, says Dr C. Ramesh. The Kidwai Memorial Institute of Oncology sees over 2,840 tobacco-related cancer ca...
Read MoreIt’s Not Just The Toy Aisles That Teach Children About Gender Stereotypes
Children are born into a world of pink or blue. A walk down a department store toy aisle demonstrates a clear gender divide: princesses and dolls for the girls, superheroes an...
Read MoreWorld No Tobacco Day 2016: WHO Appeals For Plain Packaging Of Tobacco Products.
The World No Tobacco Day is observed on May 31 every year, and this year, the World Health Organization (WHO) is calling for governments across the world to enact policies for...
Read MoreBitcoin ATMs Are Popular With The Unbanked, But The Regulatory Future Is Unclear
A trend is emerging in the Bitcoin ATM industry. Demand for the services among the underbanked and unbanked has seen steady growth in the two years since the industry’s ...
Read MoreRETROSCOPE: CELEBRATING THE LEGEND DARA SINGH
On his upcoming 97th birth anniversary, 19th November 2025, Monojit Lahiri revisits the ...
November 13 2025ALTERNATIVE ENTERTAINMENT: GHATAK, JUNG, BRECHT & PARTITION
In this profound essay, writer and filmmaker Sharad Raj explores how Ritwik Ghatak merge...
November 12 2025POWERFUL PEOPLE: JUST DO IT
In a conversation, Khalid Mohamed draws out the eventful life and film adventures of wri...
November 11 2025